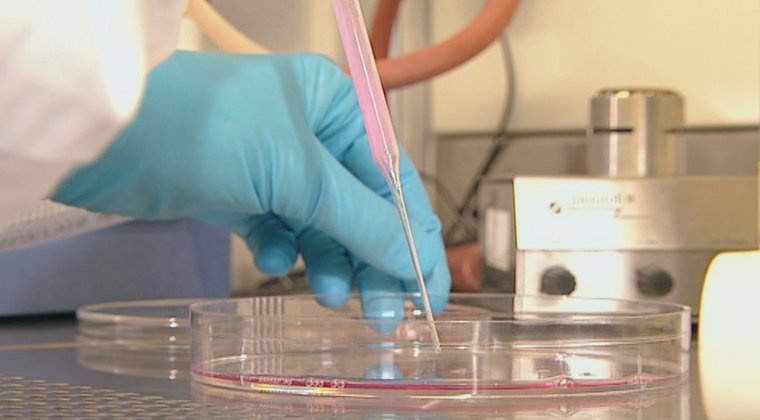
Montag, 26.10.
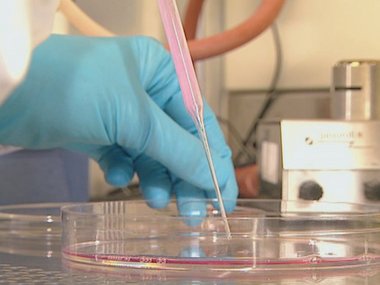
Montag, 26.10.

Update Forschung zur psychischen Gesundheit: Unser Programm
4 Institutionen informieren in Vorträgen, Diskussionen, virtuellen Laborführungen, mit Materialien für Kinder und Erwachsene
3 Tage Ein- und Ausblicke: Wo steht die Forschung zur psychischen Gesundheit in München und Augsburg, welche Themengebiete, welche Erkrankungen und welche Therapien stehen im Fokus? Sind neue Behandlungsansätze zu erwarten? Wie sieht die langfristige Perspektive aus? WissenschaftlerInnen erhalten immer genauere Einblicke in unser Gehirn, immer feinere Untersuchungsmethoden ermöglichen tiefere Erkenntnisse - und werfen gleichzeitig neue Fragen auf. Vom 26. bis 28. Oktober geben die ForscherInnen aus der Region Antworten.
Hier geht´s zum Virtuellen Labor und zum Kinderbereich
Klicken Sie auf die einzelnen Tage: